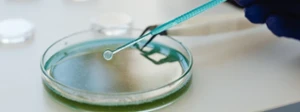

Bac Pro Animation-Enfance et Personnes Âgées
Le titulaire du Baccalauréat Professionnel Animation-Enfance et Personnes Âgées peut travailler comme animateur généraliste auprès d'un public jeune et de personnes âgées en perte d'autonomie. Il est capable de concevoir et réaliser des activités d'animation de nature variée. Il peut être amené à exercer son métier dans le secteur socioculturel et socioéducatif comme animateur enfance/jeunesse, animateur en accueil de loisirs, adjoint territorial d'animation ou dans le secteur de l'animation sociale comme animateur en Ehpad, animateur de vie sociale. L'animateur, titulaire de ce diplôme, exerce soit dans une structure relevant de la fonction publique territoriale ou hospitalière, soit dans une structure du secteur privé lucratif ou non lucratif. Ainsi, il peut travailler en maisons pour tous, maisons de quartiers, centres sociaux ou bien encore résidences autonomie et services d'aide et de maintien à domicile.
Pour plus d'informations
Cliquer sur la page du diplôme de l'ONISEP